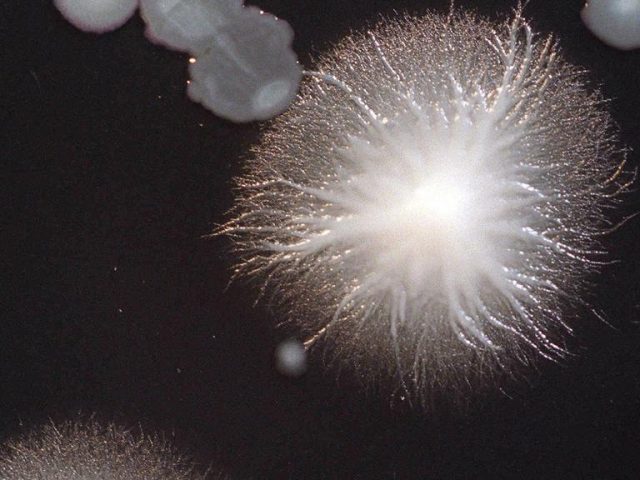

墨市爆发20年来最严重军团病疫情!确诊病例翻番至40例
2024-08-01 10:58 来源:未知 作者:Yara 浏览量:loading...
墨尔本的军团病病例突然飙升至40例,成为该市二十多年来最严重的细菌性肺炎大爆发。
卫生当局在周三晚间的最新消息中表示,另有6人为疑似病例,且已有“多人因严重”肺炎入院接受重症照护。

然而接触者追踪仍未找到疫情爆发的原因,当局仍在寻找与大部分或所有病例有关的污染水源,例如建筑物的冷却塔。
这40个病例(几乎是周一病例总数的两倍)都是在过去五天内发现的,其中“大部份”患者病情严重,需要住院治疗。

Hudson Institute of Medical Research主任哈特兰德教授(Elizabeth Hartland)表示,这是自2000年墨尔本水族馆疫情以来最大的军团病疫情,当时有150多人感染,4人死亡。
她对《先驱太阳报》(Herald Sun)说:"对澳洲来说,这绝对是一场重大的疫情。不幸的是,看起来有几个人在重症监护中,这对我来说,表明有什么东西被严重污染了,人们吸入了相当多的军团菌,所以病得很重。“
但她对疫情的未来感到乐观,并表示一旦当局提醒公众,人们通常会开始消毒潜在的水源。
她说:"通常的情况是,当人们知道有疫情爆发时,就会进行大量的冷却塔消毒,这样一来疫情通常就会消失,但真正的源头也不会被发现。因此,除非水的类型不寻常,否则疫情不会持续。”
"对于墨尔本而言,通常是冷却塔有军团菌,但也可能是温泉、水池、洗车或地基或任何有水的地方,水温比环境温度高。”

她说,重要的是要记住这种疾病不会在人与人之间传播,最好的建议是如果您有任何症状,就去接受检测。
维州在周一首次接到疫情警报,当天录得22宗病例,其后北区和西郊被列为疫情温床。
军团病的症状包括发烧、发冷、咳嗽、头痛和肌肉酸痛,吸烟者和40岁以上或免疫系统受损的人风险较高。
扫描二维码
获得房产一手资讯















